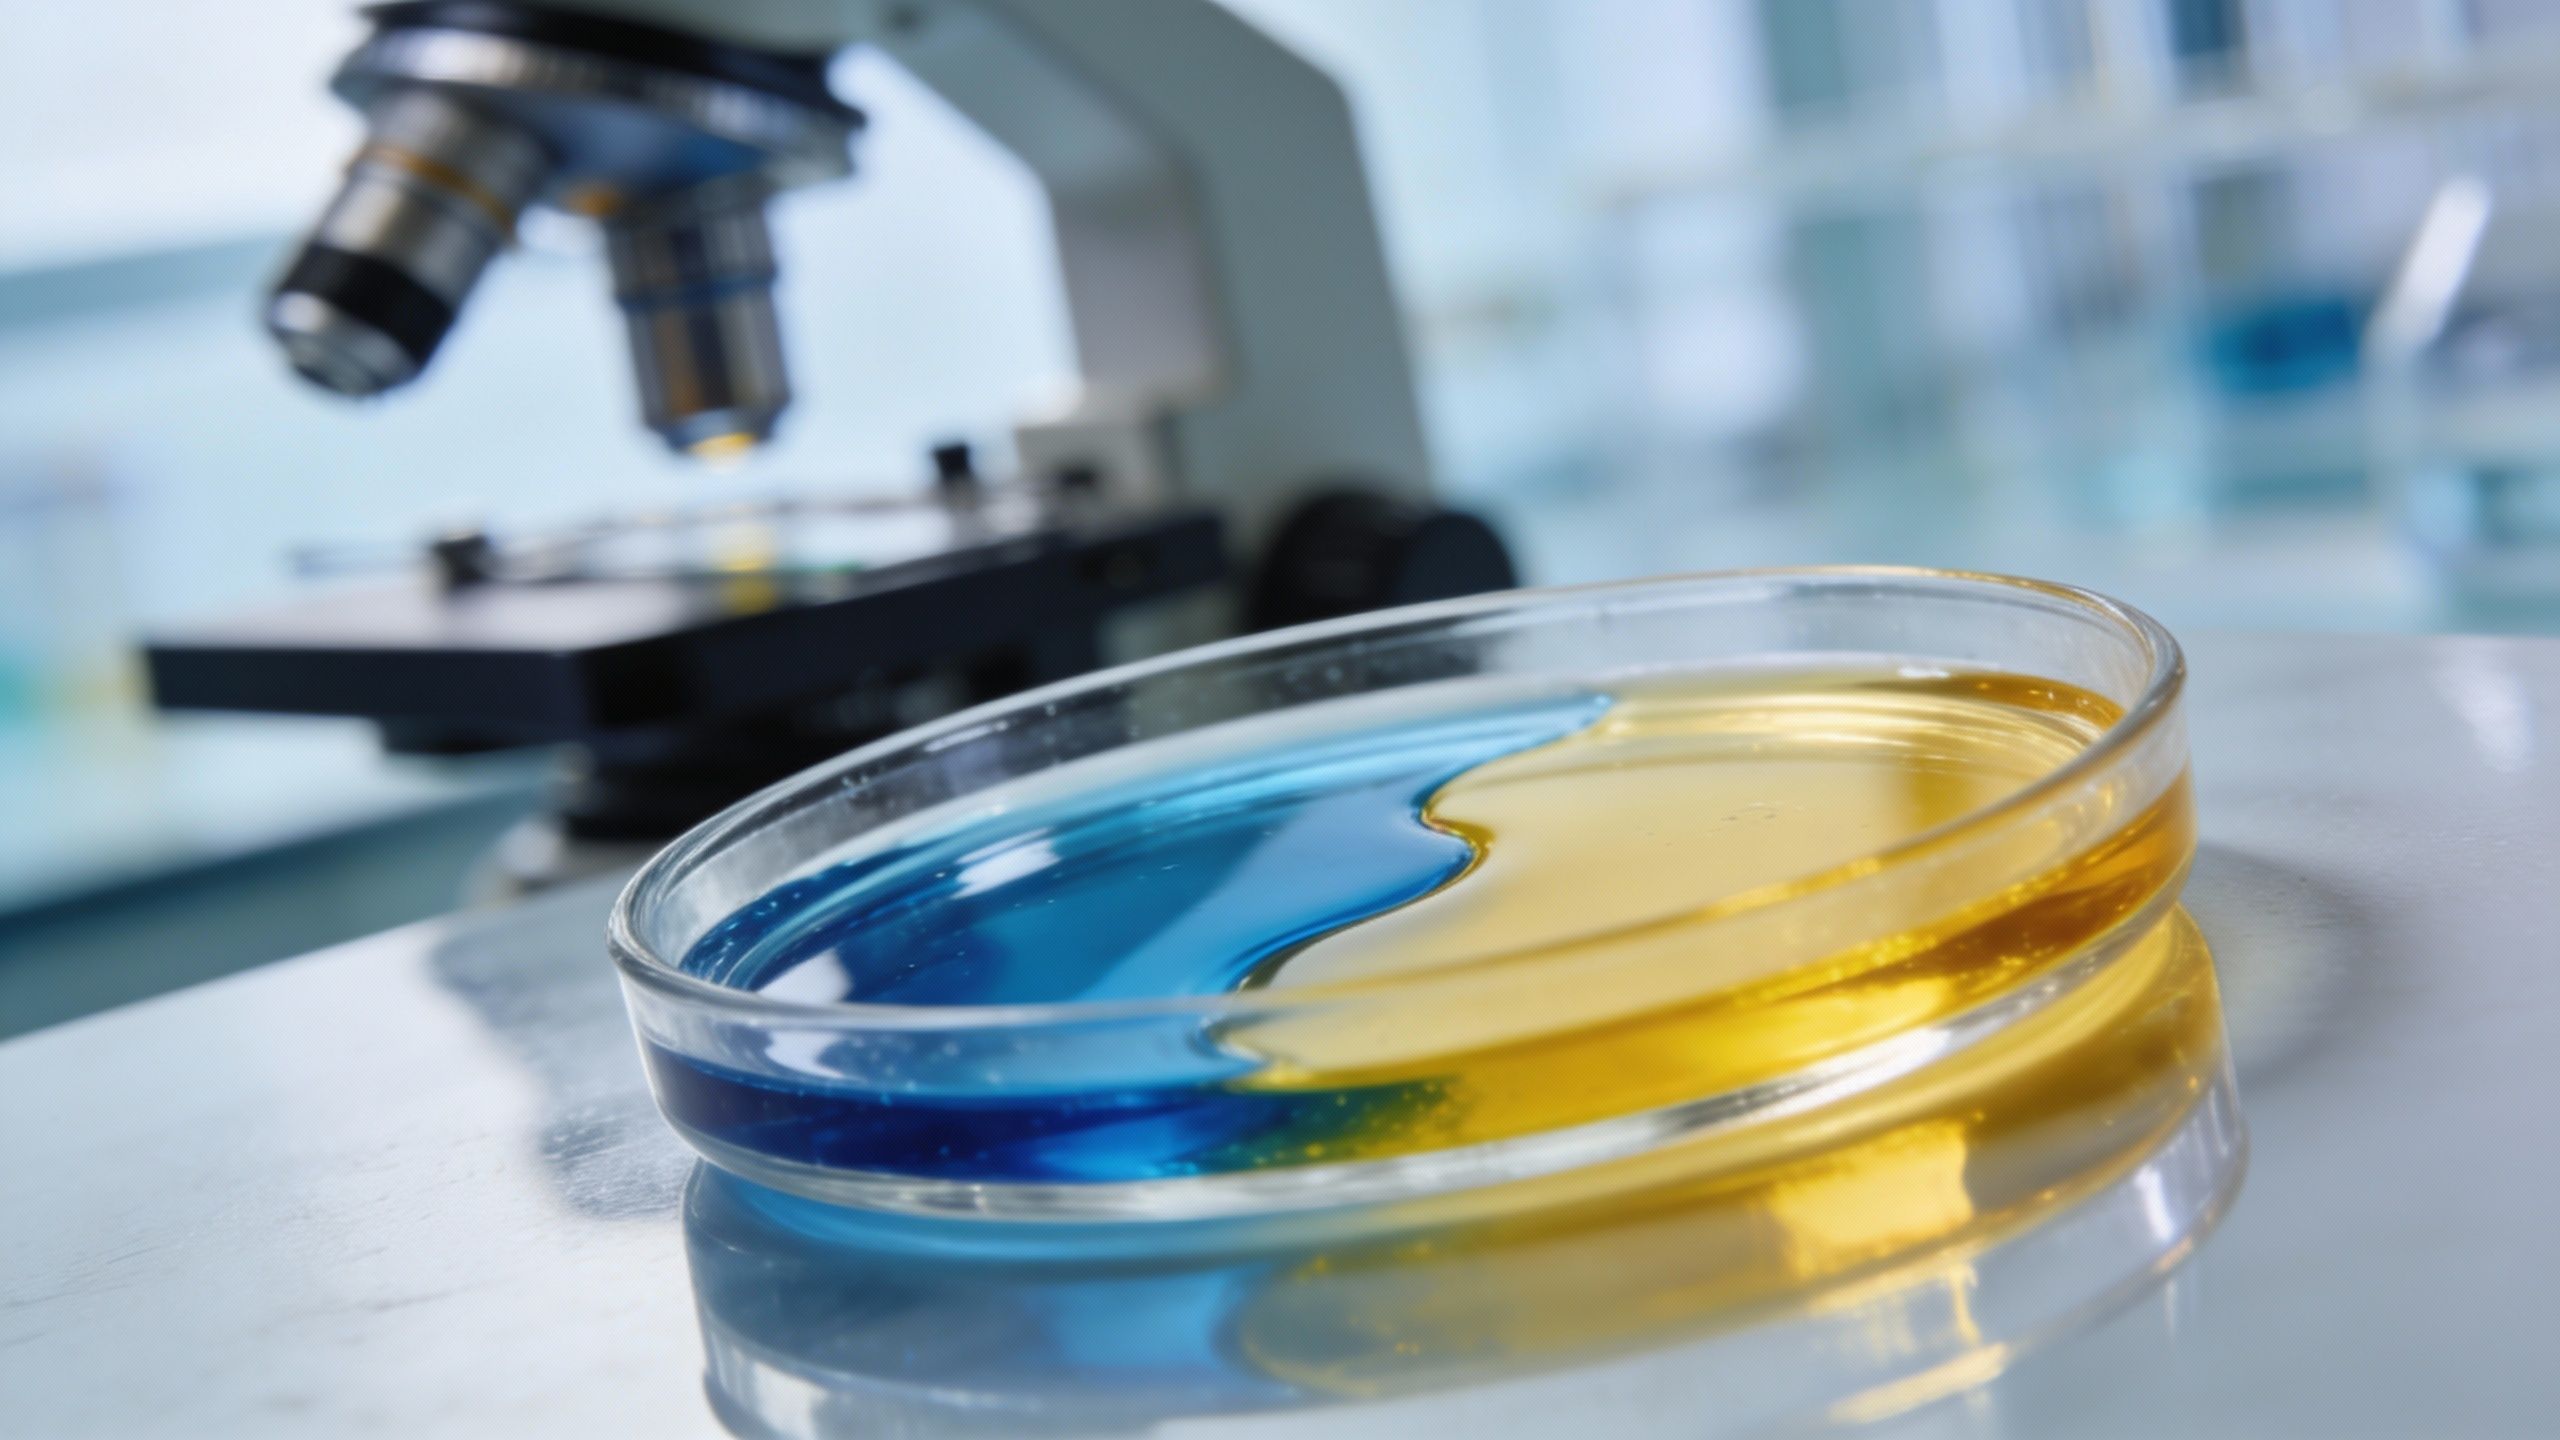

Quand le cancer apprend à se cacher

Vous savez, ce qui rend le mélanome si redoutable, ce n’est pas seulement sa vitesse de propagation. C’est sa discrétion. C’est une maladie sournoise qui parvient à glisser sous les radars de nos défenses naturelles en mourant, paradoxalement, sans attirer l’attention. Une sorte de ninja biologique, si vous voulez. Mais une équipe de chercheurs semble avoir trouvé une parade assez incroyable.
Dans une étude récente sur des souris, un nouveau traitement agit comme un véritable Cheval de Troie. L’idée ? Forcer les tumeurs à mourir d’une manière que le système immunitaire ne peut tout simplement pas ignorer. Au lieu d’une fin silencieuse, on transforme la mort des cellules cancéreuses en une alarme assourdissante.
C’est une approche fascinante menée par le Professeur Weijing Yang, un scientifique pharmaceutique de l’Université de Zhengzhou. Son travail se concentre spécifiquement sur des matériaux polymères capables de diriger nos réponses immunitaires. Et ce qu’ils ont construit ici, c’est un transporteur minuscule conçu pour livrer un stimulant immunitaire tout en modifiant la façon dont la tumeur meurt. C’est du grand art microscopique.
Au cœur du piège acide et de l’effondrement cellulaire

Alors, comment ça marche concrètement ? L’équipe a construit un nanotransporteur. Imaginez une structure minuscule conçue pour livrer une cargaison précieuse directement à l’intérieur des cellules, en toute sécurité. Ce qui est brillant, c’est la mécanique de la chose : ses blocs de polymère restent parfaitement stables dans le sang, mais dès qu’ils touchent un tissu tumoral acide, ils se relâchent. Pourquoi acide ? Eh bien, les cancers à croissance rapide brûlent leur carburant à toute vitesse, laissant traîner des ions hydrogène supplémentaires autour de leurs cellules. C’est cette acidité qui déclenche le piège.
Mais attention, ce n’est pas gagné d’avance. Même avec ce déclencheur, le transporteur doit se frayer un chemin à travers le tissu tumoral, souvent très dense et compact, ce qui reste un obstacle majeur pour beaucoup de traitements anticancéreux. Une fois à l’intérieur, par contre, c’est le chaos organisé. Le transporteur s’installe dans les mitochondries – les centrales énergétiques de la cellule – et perturbe leur utilisation de l’énergie.
Cela crée une réaction en chaîne brutale. Les groupes de polymères provoquent un stress intense, augmentant les molécules d’oxygène réactif et poussant les mitochondries endommagées à envoyer des signaux de détresse. Ce stress active ce qu’on appelle la pyroptose. C’est une mort inflammatoire qui fait littéralement éclater les membranes cellulaires. C’est violent, c’est désordonné, et c’est exactement le but. Le simple fait que le transporteur lui-même initie ce processus a permis d’éviter d’avoir à charger un médicament tueur de tumeur séparé dans les particules.
C’est ce qu’on appelle la mort cellulaire immunogène. En mourant ainsi, les cellules tumorales exposent ou relâchent des signaux de danger. Certains migrent vers la surface de la cellule, d’autres se déversent à l’extérieur. Sans ces indices chimiques clairs, les médicaments habituels (les inhibiteurs de points de contrôle) calent souvent parce que le système immunitaire n’a jamais eu un bon premier aperçu de sa cible.
Une stratégie à double cible : attaquer et reprogrammer
L’équipe ne s’est pas arrêtée là. Pour coordonner deux tâches immunitaires en même temps, ils ont visé deux choses : les cellules tumorales elles-mêmes, et les macrophages associés aux tumeurs. Ce sont des cellules immunitaires que la tumeur a, pour ainsi dire, recrutées et reprogrammées pour la servir. Des traîtres, en quelque sorte. Pour les atteindre, les chercheurs ont mélangé deux versions de leur particule. L’une portait un peptide qui se lie aux récepteurs communs sur les cellules de mélanome, tandis que l’autre transportait du mannose pour se lier aux récepteurs des macrophages.
L’objectif ? Retourner la veste de ces macrophages. Pour ce faire, le système a utilisé du resiquimod, un stimulant immunitaire qui active les capteurs innés. Une fois à l’intérieur des macrophages, ce médicament augmente la signalisation inflammatoire, les poussant vers un état qui soutient l’attaque des lymphocytes T au lieu de protéger la tumeur. Dans l’étude, les particules ciblées au mannose ont livré ce médicament avec moins de dommages pour les macrophages que ne l’auraient fait des doses plus élevées.
Cependant, soyons réalistes – et c’est là que l’humain reprend le dessus sur la théorie – cette approche ne peut pas garantir que chaque région de la tumeur reçoive les deux particules. Le flux sanguin et les tissus denses peuvent bloquer l’accès. De plus, bien que le profil de sécurité chez la souris soit encourageant, les stimulants immunitaires peuvent provoquer des effets secondaires, et rien ne garantit que cela se passera exactement pareil chez l’homme.
Conclusion : Vers un vaccin thérapeutique ?

Ce qui est fascinant, c’est l’effet « vaccin » qui suit la destruction. Après la décomposition des cellules tumorales, les fragments libérés ont entraîné les cellules dendritiques – les éclaireurs de notre système immunitaire. Celles-ci activent ensuite les lymphocytes T tueurs dans les ganglions lymphatiques, aidant le corps à reconnaître des cellules tumorales similaires ailleurs. Les particules ciblées sur la tumeur ont clairement augmenté les signes de maturation de ces cellules dendritiques.
Bien sûr, la tumeur ne se laisse pas faire. À mesure que la réponse immunitaire s’intensifiait, les tumeurs commençaient à activer des signaux de ralentissement intégrés pour calmer le jeu. Cette résistance est apparue même après que le traitement ait fait son travail. Pour contrer cela, l’équipe a dû associer le système polymère à des médicaments immunitaires largement utilisés qui bloquent ces signaux suppressifs. Chez les souris avec de plus grosses tumeurs, c’est cette approche combinée qui a conduit à la survie la plus longue.
L’imagerie a montré un signal tumoral maximal huit heures après l’injection, prouvant que les particules se concentrent bien là où il faut. Comme l’a écrit le Professeur Yang : « Cette étude fournit une stratégie pour utiliser des matériaux immunoactifs… pour augmenter la thérapie contre le cancer. » Mais gardons la tête froide. Ces résultats, publiés dans Nature Communications, proviennent de modèles murins. Les polymères nécessitent encore une fabrication à grande échelle, une purification minutieuse et des tests de sécurité à long terme. La route est encore longue, mais l’espoir est permis.
Selon la source : earth.com
Ce contenu a été créé avec l’aide de l’IA.